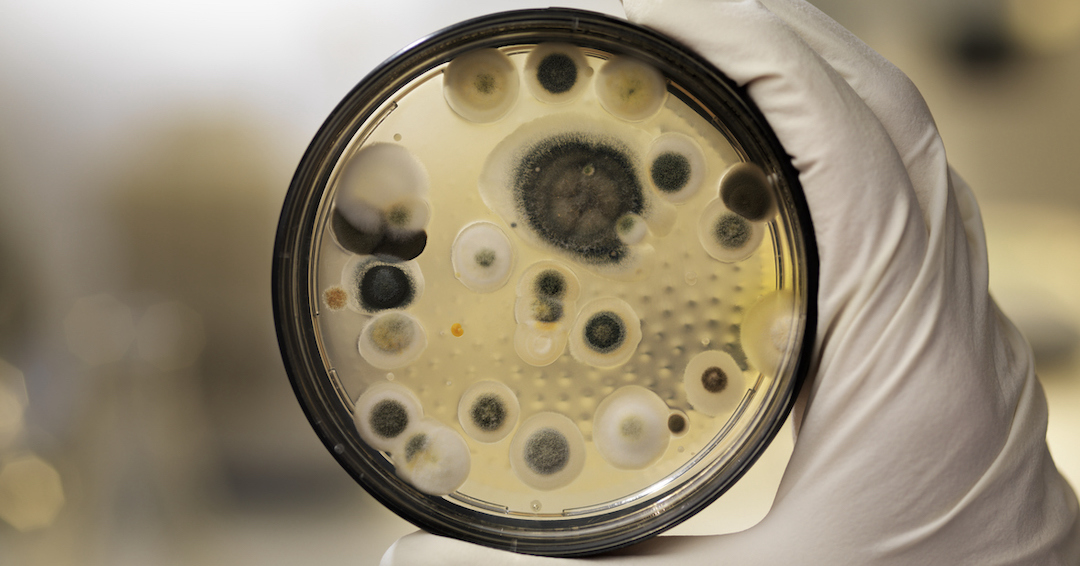

Cestas, Gironde, Nouvelle-Aquitaine – C’est une question cruciale, réactivée par le dossier glyphosate, au centre des préoccupations des agriculteurs, acteurs de santé publique et consommateurs : quelle alternative aux pesticides de synthèse ? Une question à laquelle est en train de répondre l’ingénieur agronome Laurent de Crasto (co-fondateur, agronome et CEO, Immunrise Biocontrol) et son équipe de scientifiques. La solution se trouvait au fond de l’océan !
C’est dans la Grande Bleue qu’en 2015 le chercheur Lionel Navarro a trouvé une microalgue antifongique, dont une des molécules éradique naturellement les champignons responsables du mildiou, qui attaque les vignes. Une molécule qui pourrait avoir un champ d’action beaucoup plus large : “Nous avons identifié une souche létale pour la plupart des champignons et autres pathogènes de la vigne mais aussi de nombreuses cultures”, explique Laurent de Crastro.
Une innovation “prête à l’emploi”
Développement de la méthode de production, essais sur des plants (de Mouton-Rothschild et Haut-Lafitte !), formulation et stabilisation de la molécule : apanage de la dynamique start-up, le projet s’est rapidement transformé en innovation « prête à l’emploi ». “Actuellement, nous en sommes à la phase de finalisation du produit pour sa commercialisation et son homologation pour l’obtention d’une autorisation de mise sur le marché“, poursuit le PDG d’ImmunRise BioControl. Une longue attente commence. La commercialisation ne devrait pas avoir lieu avant
2026/2027 aux États-Unis et en 2028 en France : “Un délai trop long, regrette Laurent de Crasto. Surtout lorsqu’il s’agit d’un produit à haute valeur ajoutée, 100 % biodégradable, sans impact sur la santé, qui génère beaucoup d’attente : de plus en plus de produits chimiques sont interdits mais il existe peu d’alternatives du fait du peu d’actifs répertoriés.”